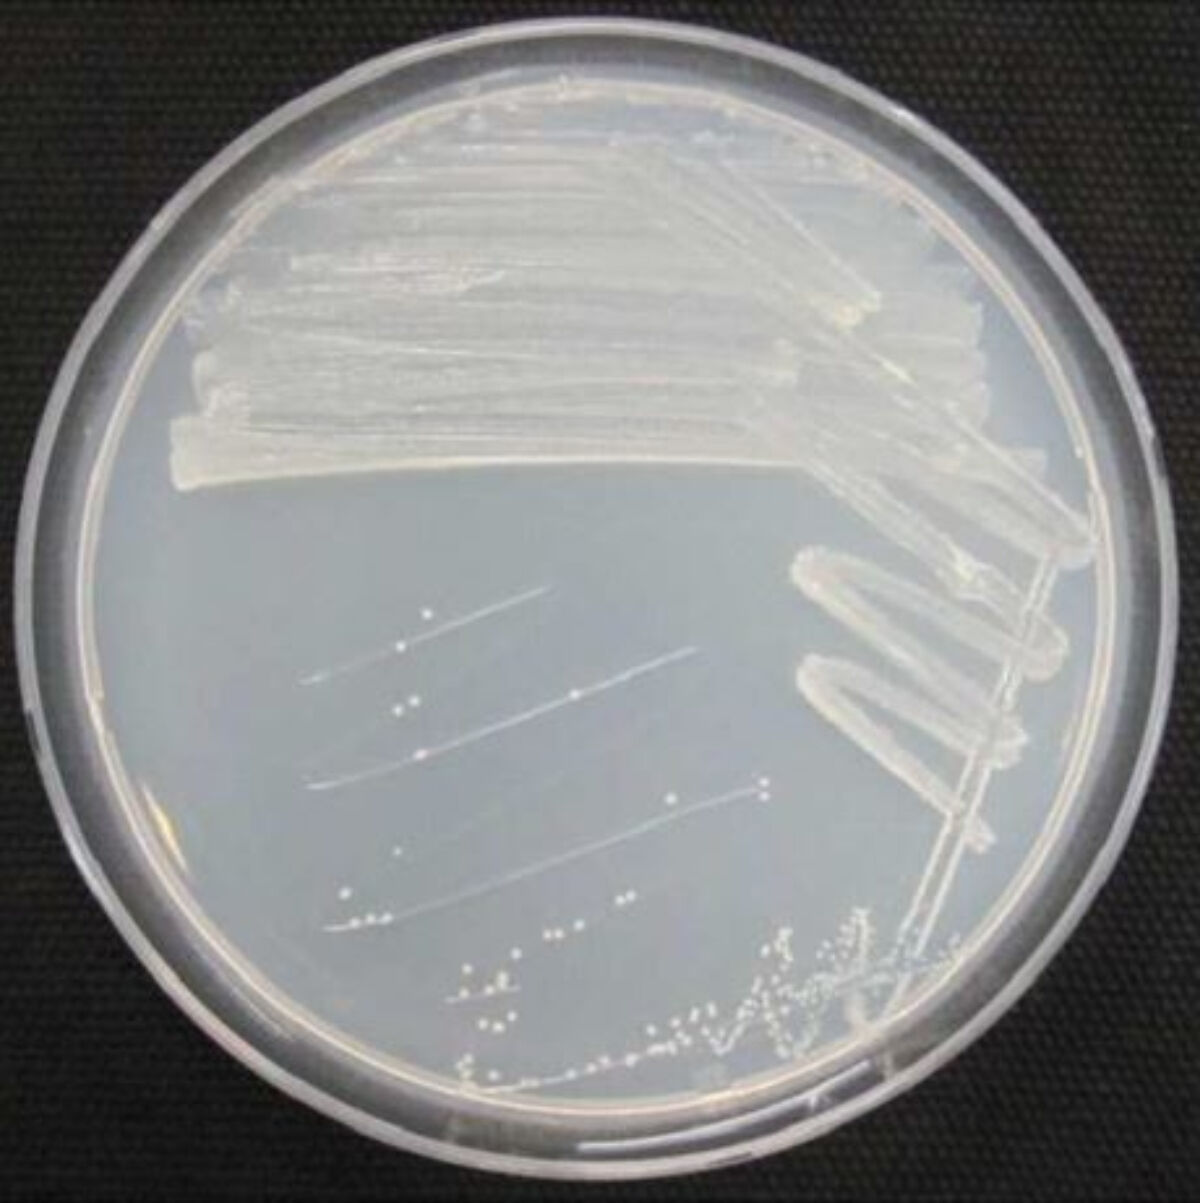
피그멘티파가 쿨라이(Pigmentiphaga kullae) 균주(사진= 안정성평가연구소)

향후 이 미생물이 화학 분야 오염을 정화하는 친환경 기술로도 활용될 수 있을지 귀추가 주목됩니다.
안전성평가연구소는 최근 국내 하천에서 채취한 '피그멘티파가 쿨라이'라는 균주가 유해 화학물질인 다환방향족탄화수소(이하 PAHs)를 분해하는 사실을 확인해 특허 등록까지 완료했다고 27일 밝혔습니다.
PAHs는 미국환경보호국(EPA)에서 지정한 환경 오염 물질로, 자동차 배기 가스나 폐기물 소각 등 화석 연료 연소 과정에서 주로 발생하며 인체와 접촉할 경우 암 또는 돌연변이를 일으킬 정도로 독성이 강한 것으로 알려져 있습니다.
연구소 측은 PAHs를 분해하기 위해 국내 하천에서 미생물이 포함된 시료를 채취해 실험실로 운반했습니다.
이후 미생물 선별 작업을 마친 결과, '피그멘티파가 쿨라이'계의 새로운 균주가 PAHs를 분해한다는 사실을 확인했습니다.
▲
피그멘티파가 쿨라이(Pigmentiphaga kullae) 균주
연구진은 산성도, 염도, 온도 조건을 달리해 이 균주를 7일간 배양했고, 그 결과 배양 시간에 따라 분해율이 증가했습니다.
하루가 지난 뒤 48.2%, 3일 후 83.7%, 5일 후 86.1% 까지 증가하더니, 일주일째 되는 날에는 96.9%까지 분해됐습니다.
또 분해를 촉진시키는 화합물(HPCD)을 첨가했을 때는 균주를 배양한 지 5일 만에 100%로 빠르게 분해되기도 했습니다.
아울러 pH 6.0~7.0, 온도 30℃, 염도 0~0.5%인 환경에서 최적으로 분해된다는 사실도 함께 확인했습니다.
이미 많은 국가에서 PHAs로 인한 환경 오염을 해결하기 위한 생물 정화 연구가 진행 중이지만 PHAs 분자의 크기가 커질수록 생분해 속도가 감소되는 등 연구의 제약이 있었습니다.
그러나 이번 연구에서는 피그멘티파가 쿨라이계 새로운 균주가 저분자량·고분자량 PAHs를 모두 생분해할 수 있다는 사실을 밝혀냈다는 점에서 의의가 있습니다.
김종환 환경안전성평가센터장은 "유해 환경이 인체 위해성과 유기적으로 연관되어 건강과 안전을 위협할 수 있어 환경 정화 기술이 중요해지고 있다"라며 "유해화학물질을 분해할 수 있는 고분해능 미생물 발굴과 생분해성 기술로 친환경 오염 정화 기술 개발에 기여해나갈 예정"이라고 밝혔습니다.
(사진=안정성평가연구소)


 동영상 기사
동영상 기사
 동영상 기사
동영상 기사
 동영상 기사
동영상 기사
 동영상 기사
동영상 기사
 동영상 기사
동영상 기사